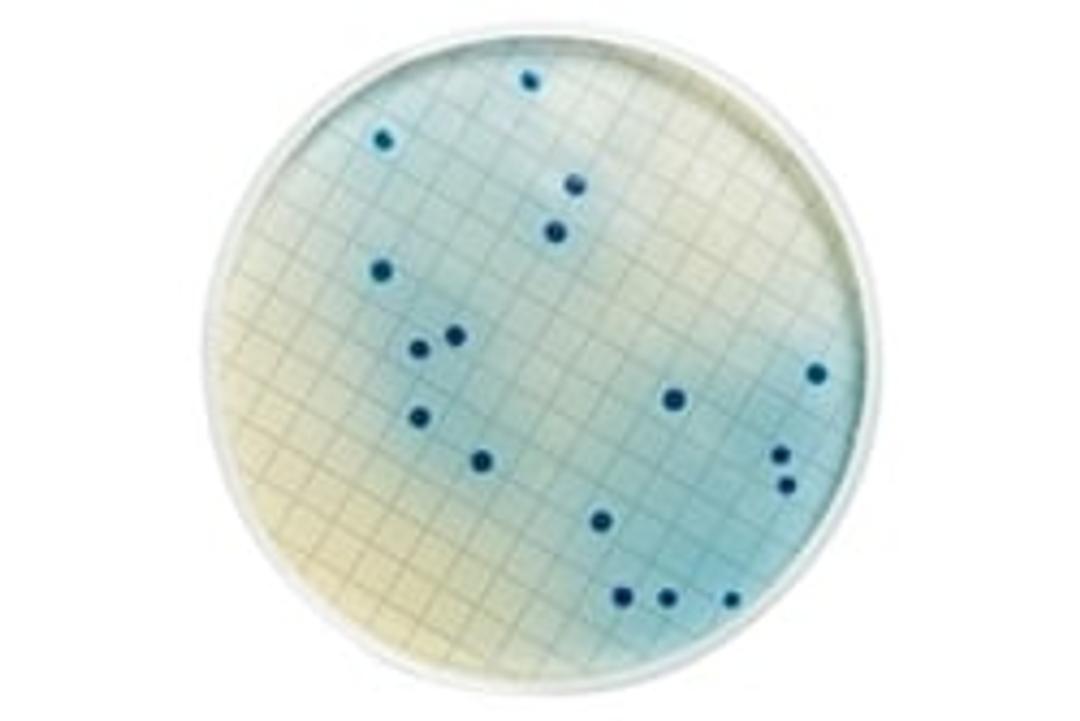
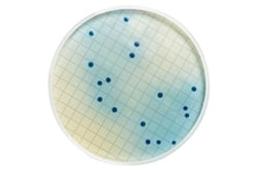

m-FC Agar
Membrane Filter Fecal Coliform Agar. Typical Composition (g/L): Proteose peptone 5.0; bile salts 1.5; tryptose 10.0; lactose 12.5; yeast extract 3.0; methyl-blue (formerly aniline blue) 0.1; sodium chloride 5.0; agar-agar 15.0.Application: For the detection of fecal coliforms in water using the membrane filter technique.

The supplier does not provide quotations for this product through SelectScience. You can search for similar products in our Product Directory.
Microbiology
We had a problem with % recovery of faecal coliforms with this media. We did not receive a lot of help or support from the manufacturer.
Review Date: 2 Apr 2014 | Merck
Membrane Filter Fecal Coliform Agar.
Typical Composition (g/L): Proteose peptone 5.0; bile salts 1.5; tryptose 10.0; lactose 12.5; yeast extract 3.0; methyl-blue (formerly aniline blue) 0.1; sodium chloride 5.0; agar-agar 15.0.
Application: For the detection of fecal coliforms in water using the membrane filter technique.